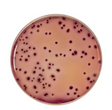

VRBG Agar, flacon à 250 ml
-
Merk
-
Merk artikelnummer
Afbeeldingen dienen ter illustratie. Product kan afwijken van de getoonde foto.
Disclaimer
De chemicaliën in deze categorie zijn uitsluitend bedoeld voor professioneel laboratorium-, onderzoeks- of onderwijsgebruik door bevoegde organisaties en personen. Controleer vóór aankoop en toepassing altijd het meest recente veiligheidsinformatieblad (SDS), de lokale wet- en regelgeving (o.a. REACH, CLP, ADR) en de interne veiligheidsvoorschriften. Onjuist gebruik, opslag of verwijdering kan leiden tot ernstige gezondheids-, milieu- of materiële schade. Antonides aanvaardt geen aansprakelijkheid voor schade die voortvloeit uit onjuist of onveilig gebruik van de producten.
De chemicaliën in deze categorie zijn uitsluitend bedoeld voor professioneel laboratorium-, onderzoeks- of onderwijsgebruik door bevoegde organisaties en personen. Controleer vóór aankoop en toepassing altijd het meest recente veiligheidsinformatieblad (SDS), de lokale wet- en regelgeving (o.a. REACH, CLP, ADR) en de interne veiligheidsvoorschriften. Onjuist gebruik, opslag of verwijdering kan leiden tot ernstige gezondheids-, milieu- of materiële schade. Antonides aanvaardt geen aansprakelijkheid voor schade die voortvloeit uit onjuist of onveilig gebruik van de producten.